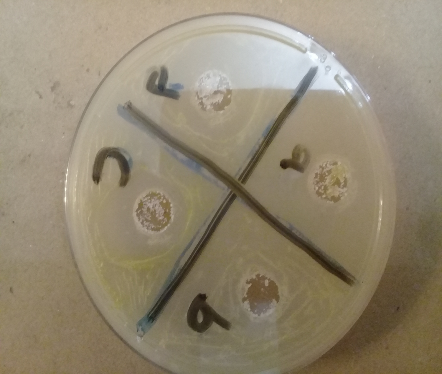
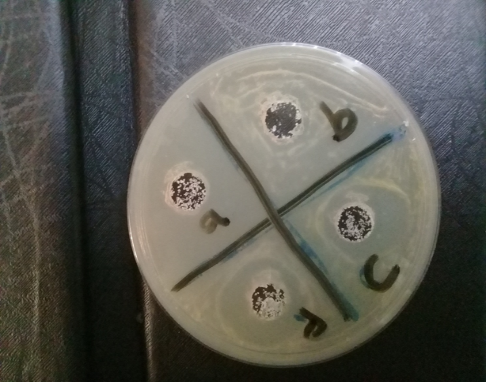

Department of Pharmaceutics and Industrial Pharmacy, Faculty of Pharmacy, Zagazig University, Zagazig, Egypt
Email: shereensabry134@yahoo.com
Received: 21 Nov 2017 Revised and Accepted: 08 Mar 2018
ABSTRACT
Objective: The principal objective of this research work was to formulate tioconazole into mucoadhesive microspheres which were inserted into the vagina for sustaining the anti-fungal activity and protecting the liver and the kidney from the harmful drug side effects.
Methods: Microspheres were prepared by the emulsion solvent evaporation method, using different ratios of the drug with either ethyl cellulose N14 or hydroxypropylmethylcellulose K100M (HPMC K100M) as mucoadhesive polymers. The formulated microspheres were evaluated for the particle size, entrapment efficiency, yield percentage, mucoadhesion strength, swelling percentage, pH, in vitro release of the drug and finally in vitro antifungal activity.
Results: The optimized formulae were F3 and F6, which showed drug entrapment of 88.4±2.5 % and 97.8±1.6 %, yield percentage of 85.0±2.3% and 95.2±1.2%, mucoadhesion strength of 31.5±1.6 and 38.1±1.6 *103 dyne/cm2, swelling percentages of 143.1±1.3 and 154.2±0.8, pH of 4.7±0.1 and 4.6±0.5, and particle size of 400±3.5 µm and435±7. 8 µm respectively. F3 and F6 released about 72.8%±3.2 and 58.4%±2.7 of the drug after 8 h respectively. F3 and F6 showed a significant anti-fungal activity.
Conclusion: Ethyl cellulose and hydroxyl propyl methylcellulose mucoadhesive microspheres are considered a good way to increase the duration of the anti-fungal activity of tioconazole with minimum side effects.
Keywords: Microspheres, Tioconazole, Mucoadhesion, Vagina
© 2018 The Authors. Published by Innovare Academic Sciences Pvt Ltd. This is an open access article under the CC BY license (http://creativecommons.org/licenses/by/4.0/)
DOI: http://dx.doi.org/10.22159/ijpps.2018v10i4.23791
Vaginal cavity is an important and alternative area for the drugs that suffer from either first pass metabolism or extensive destruction in the stomach. Increased drug administration area, rich blood supply and poor enzyme activity, encourage the researchers to choose the vagina as a route for application of several drugs, especially those have harmful impacts on the liver and the kidney like imidazole anti-fungal drugs [1].
Fortunately, mucoadhesive microspheres sustain the release of the drugs, enhance the bioavailability and increase the absorption due to the intimate contact with the vaginal mucosa [2]. Tioconazole is (RS)-1-[2-[(2-Chloro-3-thienyl) methoxy]-2-(2, 4-dichlorophenyl) ethyl]-1H-imidazole. It adversely affects both the kidney and the liver and suffers from poor bioavailability.
Hani et al. formulated clotrimazole into intravaginal microspheres by the spray drying technique, which was inserted into a mucoadhesive gel for the local treatment of vaginal candidiasis [3]. Kalita et al. increased the vaginal residence time of metronidazole through the preparation of PLC microspheres, which were incorporated into carbopol 934p and HPMC K4 M bioadhesive gel [4]. Khan and Thakur developed novel chitosan mucoadhesive microspheres for vaginal administration of tenofovir disproxil fumarate [5]. The principal intention of this research study was to formulate vaginal mucoadhesive microspheres loaded with tioconazole to avoid the harmful impacts of the oral administration of the drug on the kidney and the liver and enhancing its poor oral bioavailability through increasing the vaginal retention time of the drug.
Materials
Tioconazole was kindly supplied by Pfizer Company, Egypt. Ethyl cellulose N14, carbopol 940 (Cbp 940) and HPMC K100 M were kindly supplied by EIPICO Company, Egypt. Tween80, methylene chloride, methanol and potassium dihydrogen orthophosphate were purchased from El-Nasr Company, Egypt. All other chemicals were of analytical grade.
Table 1: Composition of different tioconazole microspheres formulations
| Formulation code | Drug: ehylcelluloseN14 ratio | Drug: HPMCK100M ratio | Cbp 940 (%W/W) | Tween 80 (%W/V) |
Time (h) | RPM |
| F1 | 1:1 | 0.5 | 1 | 1000 | ||
| F2 | 1:3 | 0.5 | 1 | 1000 | ||
| F3 | 1:5 | 0.5 | 1 | 1000 | ||
| F4 | 1:1 | 0.5 | 1 | 1000 | ||
| F5 | 1:3 | 0.5 | 1 | 1000 | ||
| F6 | 1:5 | 0.5 | 1 | 1000 | ||
| F7 | 1:5 | 1 | 0.5 | 1 | 1000 | |
| F8 | 1:5 | 2 | 0.5 | 1 | 1000 | |
| F9 | 1:5 | 1 | 0.5 | 1 | 1000 | |
| F10 | 1:5 | 2 | 0.5 | 1 | 1000 |
Cbp 940: Carbopol 940, HPMC: Hydroxy propyl methyl cellulose
Methods
Preparation of vaginal mucoadhesive microspheres
Microspheres were prepared by the emulsion solvent evaporation method. The drug and the polymer were accurately weighed by electron digital balance (Metter-Toledo, Ag, CH 8606, Greifense, Switzerland), and were dissolved into 20 ml methylene chloride at ambient room temperature. The organic phase was slowly added to 100 ml distilled water containing 0.5 % (W/V) Tween80 and emulsified by stirring at 1000 RPM using a mechanical stirrer (Heidolph PZP-2000, Germany) for 1 h. The solution was filtered, washed and dried overnight at ambient room temperature [6].
The composition of the different tioconazole microspheres formulations is given in table 1.
Characterization of microspheres
Particle size analysis
The particle size of microspheres was determined by counting 100 microspheres by using a calibrated optical microscope [7].
Yield percentage
The prepared microspheres were collected, dried and weighed. The actual weight was divided by the total weight of the starting materials. The experiment was done in triplicate.
Yield percentage
[8]
Drug entrapment efficiency
Microspheres equivalent to 10 mg of the drug were crushed, suspended in 20 ml phosphate buffer pH4.5 and stirred at 100 RPM at ambient room temperature in a thermostatic shaker water bath (Julabo SW-20 C, Germany) till equilibrium. Then, the solution was filtered, suitably diluted and the drug content was determined by RP-C18 HPLC method using methanol: phosphate buffer (70:30) adjusted to pH 4 by orthophosphoric acid as a mobile phase at a flow rate of 1.5 ml/min and UV detection at 260 nm. The experiment was done in triplicate.
Entrapment efficiency
[4]
Swelling index
The extent of the swelling was expressed as the percentage weight gained by the microspheres. 20 mg of each formula was kept in a petri dish containing phosphate buffer pH 4.5 at ambient room temperature for 4 h. At the end of the experiment, the microspheres were withdrawn and weighed. The swelling index was determined according to the following equation:
Swelling (%) 
Where W0 is the weight of the dried microspheres and Wt is the weight of the swollen microspheres after 4 h. The experiment was done in triplicate [9].
Mucoadhesion strength measurement
The mucoadhesion strength was estimated by measuring the force required to detach the microspheres from the mucin disc in between two vials using a modified balance. The modified apparatus composed of a two-arm balance, one side of which contained a plastic jar, and the other side contained two glass vials, one of the vials was attached permanently to the base of the stage, and the other was attached to the arm of the balance by a thick strong thread. Two mucin discs (E) were secured to the two glass vials (C) separately using a cyanoacrylate adhesive and a rubber band (fig.1). The microspheres (0.5 g) were applied to the mucin disc between the two vials. The height of the vial adjusted so that the spheres could adhere to the surface of both vials then, a constant weight was applied on the upper vial for 2 min, after which, it was removed and the upper vial was connected to the balance. Water was added slowly at a constant rate to a plastic jar (13–15 drops per min), until both vials were separated. The mucoadhesion strength, expressed as the detachment stress in dynes/cm2 was determined using the following equation:
Detachment stress (dynes/cm2)
[10]
Where m is the weight of water (g) that detached the two vials, gr is the acceleration due to gravity taken as 980 cm/s2, A (cm2) is the area of the mucin exposed and is equal to πr2 (r is the radius of the exposed mucin). The experiment was done in triplicate.

Fig. 1: Modified balance for measuring mucoadhesion strength: (A) Modified balance; (B) Plastic jar; (C) Glass vial; (D) Microspheres formulation; (E) Mucin; (F) Height-adjustable pan [11]
PH determination
10 mg of each formula was allowed to swell for 3 h in 25 ml distilled water. The pH of the solution was determined using a pH meter (JENCO Model-5005 USP). The experiment was done in triplicate.
In vitro release study
The cumulative release percentage of tioconazole microspheres were carried out in phosphate buffer pH4.5 for 8 h in USP-type II dissolution apparatus at 37±0.5 ° C and 100 RPM. Microspheres equivalent to 10 mg drug were used in this study. The samples were taken hourly and replaced with an equal volume of fresh release medium to maintain sink condition. After suitable dilution, samples were analyzed using HPLC-UV detection at 260 nm [12].
In vitro antifungal activity
In vitro antifungal activity of tioconazole loaded microspheres was investigated by the agar diffusion disc method [13]. Exactly four cups of 10 mm diameter were made in sabourated dextrose agar after inoculation with Candida Albicans. Two cups were filled with a calculated amount of selected microspheres and 0.5 ml distilled; sterilized water was added for microspheres wettability. The other two cups were filled with tioconazole solution as a positive control and the drug-free spheres as a negative control. The plates then were incubated at 25 ° C for 72 h. The radius of the inhibition zones was calculated and compared [14].
Kinetic analysis of the data
The data of the drug release from the tested microspheres formulations were subjected to theoretical analysis, to determine the order of kinetic release according to the following equations:
Zero-order kinetic. CT = Co–Kt.
First order kinetic. Log CT = 
Diffusion control model. Q/A=2 Co (A/π)½t½
Statistical analysis of the data
Experimental results were expressed as the mean±SD (standard deviation of the mean). One-way analysis of variance (ANOVA) was applied to check the significance. Differences were considered to be statistically significant at p<0.05 [15].
RESULTS AND DISCUSSION
Spherical, uniform and smooth surface microspheres were obtained as demonstrated in fig. 2

Fig. 2: Photomicrograph of 1:5 HPMC K100M (1:5, 0.5% Tween 80, 1000 RPM, 640 x 320 pixels)
Particle size
The mean particle size of the prepared tioconazole microspheres is given in tables 2, 4, and 5. It is greatly obvious that microspheres which were prepared with ethyl cellulose N14 (F1, F2, F3) were smaller than those prepared with HPMC K 100 M (F4, F5, F6), and this could be attributed to the impact of the polymer solution viscosity.
As a drug to polymer ratio was increased from 1:1 to1: 5, there was a comparable and significant increase in the mean particle size from 267±4.2 µm (F1) to 400±3.5 µm (F3) and from 297±6.1 µm (F4) to 435±7.8 µm (F6).
This was in a good agreement with the results of Sabry et al. [16] who found that as a drug to polymer ratio was increased from 1:1 to 1:5, the size of nizatidine micro balloons significantly increased from 230±1.9 to 324±2.6 respectively.
The increase in the polymer concentration resulted in an increase in the viscosity of the polymer solution and consequently larger particles were formed [17].
As the stirring rate was increased from 1000 to 1600 RPM, the particle size significantly decreased from 400±3.5 µm to 315±5.9 µm and from 435±7.8 µm to 335±6.3 µm, for F3 and F6 respectively. This may be due to the high shear force associated with the high speed which splits the larger droplets into smaller ones [16, 18].
The increase in Tween80 concentration from 0.5% to 1.5% resulted in a significant decrease in the particle size from 400±3.5 µm to 310±6.7 µm and from 435±7.8 µm to 332±5.3 µm for F3 and F6 respectively. Higher surfactant concentration reduces microspheres aggregation [16, 18]. Addition of Cbp940 had a non-significant effect on the particle size.
Entrapment efficiency
The results in table 2 show that the mean entrapment efficiency for F1, F2, F3, F4, F5, and F6 were 55.0±1.5, 75.2±0.8, 88.4±2.5, 69.2±2.1, 85.1±3.1, and 97.8±1.6 respectively. It is clear that there was a significant increase in the drug entrapment with an increase in the polymer concentration.
This was in a great accordance with Kalita et al. who found that metronidazole entrapment increased with an increase in HPMC K4 M concentration [4].
The increase in the polymer concentration resulted in an increase in the viscosity of the polymer solution which produced larger particles and consequently much drug was entrapped [8].
There was a reduction in the entrapment efficiency from 88.4±2.5 to 50.1±2.1, and from 97.8±1.6 to 63.6±2.6, for F3 and F6 respectively (table 4) with an increase in the stirring rate from 1000 to 1600 RPM. Higher stirring rate resulted in smaller particle size microspheres which entrap less drug.
As surfactant concentration increased from 0.5% to 1.5%, there was a significant decrease in the entrapment efficiency from 88.4±2.5 to 65. 1±1.9, and from 97.8±1.6 to 73.1±2.1, for F3 and F6 respectively (table 5). The intact and smooth microspheres will be formed at a low surfactant concentration, but as the concentration increased, the microspheres become more brittle and much drug will be lost during washing [19]. The addition of Cbp940 had a non-significant effect on the drug entrapment.
Yield percentage
Table 2 demonstrates the effect of the polymer concentration on the production yield percentage. When the drug to polymer ratio was increased from 1:1 to1: 5, there was a significant increase in the yield percentage from 59.1±1.3 (F1) to 85.0±2.3 (F3), and from 65.1±1.3 (F4) to 95. 2±1.2 (F6). A significant reduction in the yield percentage with the increase of either stirring rate [18] or surfactant concentration [20] was observed (tables 4 and 5). This could be ascribed to the formation of smaller particles which were lost during the filtration and the collection of the microspheres. It was found that the addition of Cbp940 had a non-significant effect on the yield percentage.
Mucoadhesion strength
Table 3 demonstrates mucoadhesion strength of the prepared microspheres formulae. The results showed that the microspheres which were prepared with HPMC K100 M (F4, F5, and F6), showed mucoadhesion of 32.5±1.2, 38.1±1.6, and 45.6±1.2 respectively. These results were greater than those of ethyl cellulose N14 microspheres (F1, F2, F3), which were 20.6±0.1, 26.7±1.2, and 31.5±1.6 respectively. This could be attributed to several factors. The hydroxyl groups' content of HPMC K100 M is greater than that of ethyl cellulose N14 which allows more swelling, resulting in an increase in the flexibility and consequently has more distance between its chains, which gives more hydrogen bonding with the substrate [21]. Also, HPMC K100 M has a molecular weight higher than that of ethyl cellulose N14 which suggests more adherence to the substrate [22, 23]. The results also inferred that as the polymer concentration was increased, there was a corresponding and significant increase in the mucoadhesion strength [24].
The addition of Cpb940 (F7, F8, F9, F10) produced a significant increase in the mucoadhesion and this could be ascribed to either the increased hydrogen bonding or the molecular weight or both.
Swelling percentage
The results in table 3 declare that the swelling percentages of ethyl cellulose microspheres F1, F2 and F3 were 120.5±1.5, 131.6±0.9, and 143.1±1.3 respectively and those of HPMC microspheres were133. 1±2.3, 141.6±1.6, and 154.2±0.8 respectively. The obtained results inferred that the swelling of HPMC is higher than that of ethyl cellulose, and this could be ascribed to the higher hydrophilicity of the former than the later [21]. Also, the swelling percentage significantly increased with an increase in the polymer concentration [25]. Iswarriya et al. reported an increase in the swelling of ranolazine micro balloons with an increase in sodium alginate concentration [26].
The addition of 1% Cbp940 increased the swelling from154. 2±0.8 (F6) to160. 2±1.9 (F7) and from143. 1±1.3 (F3) to150. 6±0.9 (F9). Further increase in Cbp940 concentration to 2%, resulted in a significant increase to 173.2±2.1 and 159. 6±2.1 for F8 and F10 respectively.
PH
The pH of the vagina falls within the range of 4 to 5 and that of all prepared formulae was within the range of 4.6 to 5.9, which ensures non-irritability to the vaginal mucosa.
Table 2: Particle size, yield percentage and entrapment efficiency of mucoadhesive microspheres
| Formulation code | Mean particle size (µm)±SD* | Mean yield percentage)±SD* | Mean entrapment efficiency (%)±SD* |
| F1 | 267±4.2 | 59.1±1.3 | 55.0±1.5 |
| F2 | 334±5.6 | 70.2±2.1 | 75.2±0.8 |
| F3 | 400±3.5 | 85.0±2.3 | 88.4±2.5 |
| F4 | 297±6.1 | 65.1±1.3 | 69.2±2.1 |
| F5 | 352±3.9 | 83.1±2.6 | 85.1±3.1 |
| F6 | 435±7.8 | 95.2±1.2 | 97.8±1.6 |
| F7 | 415±5.6 | 96.6±2.7 | 96.2±1.3 |
| F8 | 425±6.2 | 95.6±1.9 | 98.1±1.5 |
| F9 | 395±5.1 | 86.7±1.9 | 85.6±1.5 |
| F10 | 405±7.1 | 88.6±2.1 | 89.1±2.5 |
*Mean of three determinations±standard deviations of the mean.
Table 3: Mucoadhesion strength, swelling after 4 h and PH of mucoadhesive microspheres
| Formulation code | Mucoadhesion strength (*103dyne/cm2)±SD* | Swelling (%) after 4 h±SD* | PH±SD* |
| F1 | 20.6±0.1 | 120.5±1.5 | 4.7±0.2 |
| F2 | 26.7±1.2 | 131.6±0.9 | 4.9±0.8 |
| F3 | 31.5±1.6 | 143.1±1.3 | 4.7±0.1 |
| F4 | 26.8±0.9 | 133.1±2.3 | 4.9±0.5 |
| F5 | 32.5±1.2 | 141.6±1.6 | 5.3±0.1 |
| F6 | 38.1±1.6 | 154.2±0.8 | 4.6±0.5 |
| F7 | 45.6±1.2 | 160.2±1.9 | 4.7±0.8 |
| F8 | 51.6±0.9 | 173.2±2.1 | 4.6±0.1 |
| F9 | 36.2±1.2 | 150.6±0.9 | 5.1±0.1 |
| F10 | 43.5±0.8 | 159.6±2.1 | 4.9±0.8 |
*Mean of three determinations±standard deviations of the mean.
Table 4: Effect of stirring rate on particle size, yield percentage and entrapment efficiency
| Formulation code | RPM | Mean particle size (µm)±SD* | Mean yield percentage)±SD* | Mean entrapment efficiency (%)±SD* |
| F3 | 1000 | 400±3.5 | 85.0±2.3 | 88.4±2.5 |
| 1200 | 355±6.5 | 72.0±1.6 | 73.5±1.1 | |
| 1600 | 315±5.9 | 59.2±2.1 | 50.1±2.1 | |
| F6 | 1000 | 435±7.8 | 95.2±1.2 | 97.8±1.6 |
| 1200 | 385±7.2 | 83.1±2.1 | 81.6±2.1 | |
| 1600 | 335±6.3 | 70.5±1.5 | 63.6±2.6 |
*Mean of three determinations±standard deviations of the mean.
Table 5: Effect of Tween 80 concentration on particle size, yield percentage and entrapment efficiency
| Formulation code | Tween80 (%W/V) | Mean particle size (µm)±SD* | Mean yield percentage)±SD* | Mean entrapment efficiency (%)±SD* |
| F3 | 0.5 | 400±3.5 | 85.0±2.3 | 88.4±2.5 |
| 1.0 | 352±6.1 | 74.6±1.7 | 76.3±1.6 | |
| 1.5 | 310±6.7 | 61.6±2.1 | 65.1±1.9 | |
| F6 | 0.5 | 435±7.8 | 95.2±1.2 | 97.8±1.6 |
| 1.0 | 385±5.3 | 86.2±1.6 | 85.1±2.5 | |
| 1.5 | 332±5.3 | 76.4±1.5 | 73.1±2.1 |
*Mean of three determinations±standard deviation of the mean.
In vitro release study
The release of tioconazole from all prepared microspheres formulations followed Higuchi diffusion model. The effect of the polymer type and polymer concentration is shown in fig. 3 and 4. It is obvious that the cumulative release percentages of the drug from F1, F2 and F3 were greater than those from F4, F5 and F6. The increase of the drug to polymer ratio from 1:1 to 1:5, resulted in a significant decrease in the percentage of tioconazole which released after 8 h from 74.1±0.6 (F4) to 58.4±0.3 (F6), and from 88.2±0.5 (F1) to 72.8±0.3 (F3).
The increase of the polymer concentration increases the swelling of the polymer matrix and the diffusional path length, which might delay the release [27-29].
The hydration capacity of the polymer increased with the addition of Cbp940. It formed a gelatinous mass when came into contact with the dissolution medium and retarded the release of the drug [30]. This explains the decrease in the cumulative release percentage upon adding Cbp940 (fig. 5 and 6). Sarfaraz reported a decrease in rifampicin release from 91.2% to 81.7% with the increase of drug to Cbp974 ratio from 1: 1 to 1:2 [31]. The increase of the stirring rate from 1000 to 1600, resulting in an increase in the cumulative release percentages from 58.4±0.3 to 79.1±0.8 and from 72.8±0.3 to 90.2±0.9, for F6 and F3 respectively (fig. 7and 8). Smaller microspheres with the larger surface area were formed at a higher stirring rate, which suggested the increase in the cumulative release percentage after 8 h [20]. Fig. 9 and 10 show that an increase in the surfactant concentration to 1.5% increased the cumulative release to 78.1±and 87.6±0.5, for F3 and F6 respectively. The increased surfactant concentration gave porous microspheres which resulted in higher release percentages [19, 32].

Fig. 3: Effect of tioconazole: ethyl cellulose ratio on the cumulative release of tioconazole, Number of experiments=3

Fig. 4: Effect of tioconazole: HPMC ratio on the cumulative release of tioconazole, number of experiments=3

Fig. 5: Effect of Cbp940 on the cumulative release of tioconazole from ethyl cellulose microspheres, number of experiments=3

Fig. 6: Effect of Cbp940 on the cumulative release of tioconazole from HPMC microspheres, number of experiments=3

Fig. 7: Effect of stirring rate on the cumulative release of tioconazole from ethyl cellulose microspheres, number of experiments=3

Fig. 8: Effect of stirring rate on the cumulative release of tioconazole from HPMC microspheres, number of experiments=3

Fig. 9: Effect of Tween 80 concentration on the cumulative release of tioconazole from ethyl cellulose microspheres, number of experiments=3

Fig.10: Effect of Tween 80 concentration on the cumulative release of tioconazole from HPMC microspheres, number of experiments=3
In vitro antifungal activity
The results in table 6, fig. 11 and 12 exhibit the inhibition zones of the tested formulae F3 and F6 respectively. Tioconazole free microspheres showed zero inhibition zones, which indicated non anti-fungal activity.
Tioconazole solution showed an inhibition zone of 43±2.6 mm. For F3 and F6, the inhibition zones were 47.6±0.6 and 52.3±1.5 respectively.
From the previous results, it can be concluded that both ethyl cellulose and HPMC loaded tioconazole mucoadhesion microspheres produced a significant antifungal activity against Candida Albicans.
Fig.11: Inhibition zones of F3 and tioconazole, number of experiments=3
a=tioconazole free ethyl cellulose microspheres, b= Tioconazole solution, c and d=F3
Fig.12: Inhibition zones of F6 and tioconazole, number of experiments=3
a=tioconazole free HPMC microspheres, b= Tioconazole solution, c and d=F6
Table 6: In vitro antifungal activity of tioconazole formulations
| Formula | Zone of inhibition (mm)±S. D* |
| Tioconazole solution | 43±2.6 |
| Tioconazole free ethyl cellulose microspheres, control | 0 |
| Tioconazole free HPMC microspheres, control | 0 |
| F3 | 47.6±0.5 |
| F6 | 52.3±1.5 |
*Mean of three determinations±standard deviations of the mean.
Both ethyl cellulose and HPMC mucoadhesive microspheres had achieved the goal of this study through an increase in the retention time of the drug inside the vagina, which reflected by the high mucoadhesion strength, the delayed release and the significant anti-fungal activity against Candida Albicans. It can be concluded that both ethyl cellulose and HPMC mucoadhesive microspheres are considered promising tools to enhance both the vaginal availability and bioavailability.
The author is thankful to micro-analytical center, faculty of science, Cairo University for conducting in vitro anti-fungal studies.
The corresponding author Shereen Ahmed Sabry had developed the experimental section of the work, writing up and correction of the manuscript. Microanalytical center, faculty of science, Cairo University is responsible for the conduction of the anti-fungal studies.
The author reports no conflict of interest
Muraleedhara KK, Senthil Kumar SK, Parthiban S. Mucoadhesive vaginal drug delivery system: a review on advance status. Int J Pharm Res Anal 2013;3:33-46.
Shivanand P. Different techniques of formulation and evaluation of mucoadhesive microspheres. Int J Pharma Bio Sci 2010;1:1-7.
Hani U, Shivakumar HG, Gowrav MP. Formulation and evaluation of a novel vaginal delivery system of clotrimazole. Int J Pharm Sci Res 2014;5:220-7.
Kalita BS, Aikia KS, Kalita B. Formulation and evaluation of metronidazole microspheres-loaded bioadhesive vaginal gel. Asian J Pharm Clin Res 2017;10:418-24.
Khan AB, Thakur RS. Formulation and evaluation of mucoadhesive microspheres of tenofovir disoproxil fumarate for intravaginal use. Curr Drug Delivery 2014;11:112-22.
Mukerjee A, Sinha VR, Pruthi V. Preparation and characterization of poly-ε-car polactone particles for controlled insulin delivery. J Biomed Pharm Eng 2007;1:40-4.
Wu XG, Li G, Gao YL. Optimization of the preparation of nalmefene-loaded sustained-release microspheres using central composite design. Chem Pharm Bull 2006;54:977-81.
Parmar A, Mishra A, Pathak A. Preparation and evaluation of mucoadhesive microspheres of repaglinide for treatment of diabetes mellitus typeII. Int J Adv Pharm 2015;4:72-82.
Chowdhury JA, Jahan ST, Morshed MM, Mallick J, Nath AK, Uddin MZ, et al. Development and evaluation of diclofenac sodium loaded alginate cross-linking beads. Bangladesh Pharm J 2011;14:41-8.
Khan S, Patil K, Bobade N, Yeole P, Gaikwad R. Formulation and intranasal mucoadhesive temperature-mediated in-situ gel containing ropinirole and evaluation of brain targeting efficiency in rats. J Drug Target 2010;18:223-34.
Sulayman HT. Some variable affecting the formulation of tinidazole mucoadhesive oral gel. Al-Mustansiriyah J Pharm Sci 2011;1:407-19.
Wen B, Long Y, Mao ZM. Determination of the content and the related substances of tioconazole by HPLC. Chinese J Antibiol 2007;32:163-5.
Rathore GS, Tanwar YS, Naruka PS. Comparative evaluation of in vitro antifungal activity of ethosomal and liposomal gel formulated with fluconazole for treatment of deep fungal skin infection. Asian J Pharm Edu Res 2015;4:60-6.
Helal DA, Abdel-Halim SA, EL-Nabarawi MA. Formulation and evaluation of fluconazole topical gel. Int J Pharm Pharm Sci 2012;4:176-83.
Patel N, Padia N, Vadgama N. Formulation and evaluation of microsponge gel for topical delivery of fluconazole for fungal therapy. J Pharm Investig 2016(a);46:221-38.
Sabry SA, Hasan MH, Abdallah MH. Gastroretentive nizatidine loading micro balloons for treatment of peptic ulcer. Int J Pharm Pharm Sci 2015;7:220-5.
Najmuddin M, Ahmed A, Shelar S, Patel V, Khan T. Floating microspheres of ketoprofen: formulation and evaluation. Int J Pharm Pharm Sci 2010;2:164-8.
Nepal PR, Chun MK, Choi HK. Preparation of floating microspheres for fish farming. Int J Pharm 2007;341:85-90.
Lin SY, Tzan YL, Weng CN, Lee CJ. Preparation of enteric coated microspheres of mycoplasma hyopnumoniae vaccine with cellulose acetate phthalate: 1. formulation condition and micrometric properties. J Microencapsul 1991;8:317-25.
Mazumder B, Bhattacharya S, Mohanta B, Dey S, Maity A. Preparation and in vitro evaluation of chlorpheniramine maleate loaded microspheres. Int J PharmTech Res 2009;1:905-13.
Gavini V, Ragini B, Kaumudi K. Mucoadhesive microspheres-a novel approach of drug targeting. World J Pharm Pharm Sci 2014;3:310-35.
Gurny R, Meyer JM, Peppas NA. Bioadhesive intra oral release system: design, testing and analysis. Biomaterials 1984;5:336-40.
Kamath KR, Park K. Mucosal adhesive preparations. In Encyclopedia Pharma Tech 1995;12:132-62.
Velmurugan S, Ali MA. Development and evaluation of ritonavir mucoadhesive microspheres. Asian J Pharm Clin Res 2014;7:47-52.
Manjanna KM, Shivakumar B, Pramod Kumar TM. Formulation of oral sustained release aceclofenac sodium microbeads. Int J Pharm Tech Res 2009;1:940-52.
Iswariya VT, Soujanya GL, Santhosh R, Kumar AP, Lingaswamy J, Satyanarayana K. Design and development of in vitro characterization of floating microspheres of ranolazine. Eur J Pharm Med Res 2016;3:220-32.
Jelvehgari M, Mobaraki V, Montazam SH. Preparation and evaluation of mucoadhesive beads/discs of alginate and algino-pectinate of piroxicam for colon-specific drug delivery via oral route. Jundishapur J Nat Pharm Prod 2014(b);9:1-10.
Muruganantham V, Jaykar B. Design and evaluation of microspheres of midazolam. Asian J Res Biol Pharm Sci 2016;4:13-20.
Deshmukh MT, Mohite SK. Formulation and characterization of olanzapine-loaded mucoadhesive microspheres. Asian J Pharm Clin Res 2017;10:249-55.
Hua S, Ma H, Li X, Yang H, Wang A. pH sensitive sodium alginate/polyvinyl acohol hydrogel beads prepared by combined Ca±2 cross linking and freeze-thawing cycles for controlled release of diclofenac sodium. Int J Biol Macromol 2010;46:517-23.
Sarfaraz MD, Hiremath D, Chowdary KPR. Formulation and characterization of rifampicin microcapsules. Ind J Pharm Sci 2010;72:101-5.
Lewis L, Boni R, Adeyeye CM. Effect of emulsifier blend on the characteristics of sustained release diclofenac microspheres. J Microencapsul 1998;15:283-98.